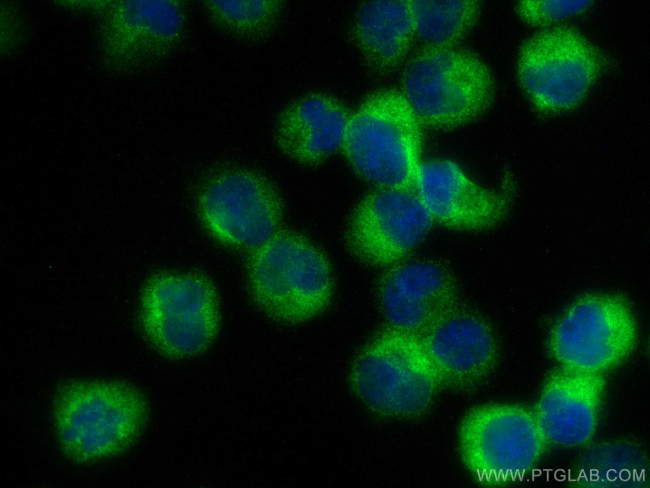
DOCK2 Antibody in Immunocytochemistry (ICC/IF)
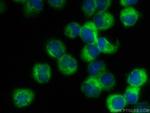
DOCK2 Antibody in Immunocytochemistry (ICC/IF)

Search
Proteintech
DOCK2 Polyclonal Antibody
{{$productOrderCtrl.translations['antibody.pdp.commerceCard.promotion.promotions']}}
{{$productOrderCtrl.translations['antibody.pdp.commerceCard.promotion.viewpromo']}}
{{$productOrderCtrl.translations['antibody.pdp.commerceCard.promotion.promocode']}}: {{promo.promoCode}} {{promo.promoTitle}} {{promo.promoDescription}}. {{$productOrderCtrl.translations['antibody.pdp.commerceCard.promotion.learnmore']}}
产品信息
20245-1-AP
种属反应
宿主/亚型
分类
类型
抗原
偶联物
形式
浓度
规格
纯化类型
保存液
内含物
保存条件
运输条件
靶标信息
Dedicator of cytokinesis 2 (DOCK2) is a gene located on chromosome 5q15, encoding a member of the DOCK family of guanine nucleotide exchange factors (GEFs). DOCK2 plays a crucial role in the immune system by regulating the actin cytoskeleton, which is essential for cell movement and immune cell activation. It is predominantly expressed in hematopoietic cells, including lymphocytes and other leukocytes, where it facilitates chemotaxis and polarization by activating the small GTPase Rac. This activation is critical for processes such as lymphocyte homing, migration towards chemokines, and phagocytosis. Genetic mutations or dysregulation of DOCK2 can lead to immunodeficiency, characterized by impaired immune responses and increased susceptibility to infections. Research into DOCK2 focuses on its therapeutic potential in modulating immune responses and its role in disorders characterized by immune dysregulation, such as autoimmune diseases and chronic inflammation.
仅用于科研。不用于诊断过程。未经明确授权不得转售。
篇参考文献 (0)
生物信息学
蛋白别名: dedicator of cyto-kinesis 2; Dedicator of cytokinesis protein 2; FLJ46592; KIAA0209; unnamed protein product
基因别名: DOCK2; IMD40; KIAA0209
UniProt ID: (Human) Q92608
Entrez Gene ID: (Human) 1794